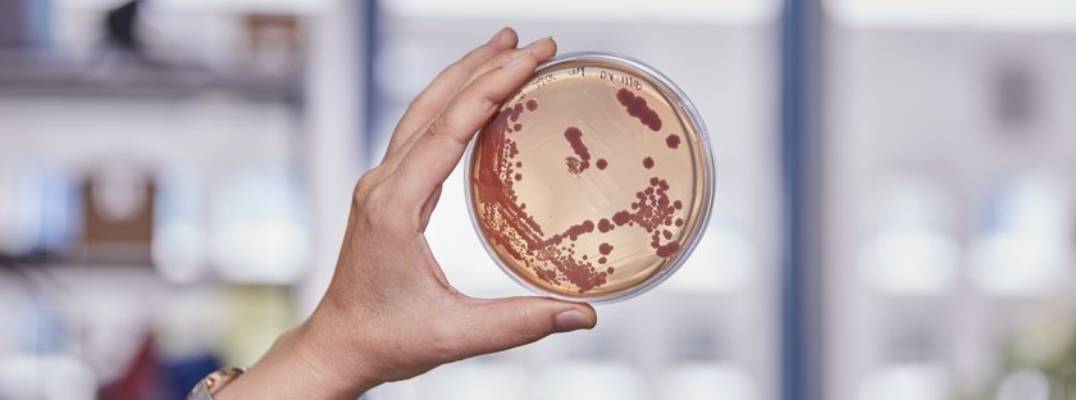
Insight Bacteriology Invites New Submissions: A Gateway to Global Microbial Research

The global scientific community is invited to submit their valuable research manuscripts to Insight Bacteriology, a distinguished international journal published annually by Insight Knowledge. As a double-blind, peer-reviewed, open-access platform, Insight Bacteriology is dedicated to disseminating impactful basic and applied research focusing on bacteria and other microorganisms.
The journal's broad scope covers diverse topics including morphology, ecology, genetics, enzymology, metabolism and regulation, molecular biology, plasmids, transposons, and the biochemical aspects of bacterial research. Manuscripts undergo rigorous evaluation based on scientific validity, methodological soundness, relevance, clarity, and strict adherence to ethical standards, ensuring each publication significantly contributes to the scientific community.
Researchers benefit from rapid editorial decisions and swift online publication. Insight Bacteriology is prominently indexed in renowned academic databases such as the Asian Digital Library, ASCI-Database, Google Scholar, JournalsPedia, and Open Access Asia, guaranteeing global visibility and extensive readership.
An esteemed Editorial Board comprising internationally recognized experts ensures quality management of each submitted paper, supported by personalized service from dedicated in-house staff.
The journal maintains stringent ethical policies aligned with the guidelines provided by the Committee on Publication Ethics (COPE) and the Asian Council of Science Editors, thus upholding high standards in scientific publishing.
Researchers, academicians, and industry professionals are encouraged to submit their manuscripts for consideration. Insight Bacteriology offers an exceptional opportunity for your research to reach a broad audience, fostering collaboration and accelerating advancements in microbial science.
Submit your manuscripts today to become a part of the dynamic global bacteriology research community!